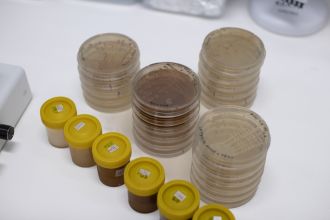
Experiment testing antimicrobial effectiveness of honey on bacteria

News release
From:
Aussie native ‘buffet’ creates honey with stronger anti-microbial punch
Honeybees collecting nectar from a ‘buffet’ of Australian native plants made honey with anti-microbial abilities that is more potent than ‘single origin’ honey made from only one source of plant or flower, a University of Sydney-led study has found.
The findings could help develop new treatments for drug-resistant infections while supporting bushfire recovery and sustainable beekeeping practices across Australia. They also place native Australian honey as a strong competitor on the global landscape.
The World Health Organisation has declared antimicrobial resistance one of the top 10 global public health threats facing humanity, driving interest in the medicinal value and potent antimicrobial activity of honey. Reports of critical antibiotic resistance in Australia increased by more than 25 per cent in 2024.
The study was 5 years in the making. The researchers analysed the antimicrobial activity and chemical composition of 56 honey samples collected at more than 35 apiaries, including areas recovering from the devastating 2020 bushfires in New South Wales and Victoria. It was reported that a total of 9,809 hives were reported by industry as being completely burnt and 88,094 hives had forager bees killed by the fires.
The research, published in Microbiology Open, found more than three-quarters of honey samples made native plants such Eucalyptus could kill dangerous bacteria, even when the honey was diluted to 10 percent or less.
The study found that honey made from mixed floral sources had a superior performance against bacteria, with high levels of bioactive compounds such as hydrogen peroxide, phenolics, and antioxidants compared to honey from one source.
The study tested the honeys against Escherichia coli and Staphylococcus aureus (known as golden staph), two bacteria that are among the six leading pathogens for deaths associated with antibiotic resistance. Golden Staph is a common cause of skin infections. Some types of E. coli and Staph aureus bacteria have developed resistance to our existing antibiotic drugs, becoming superbugs. That makes infections very hard to treat, and means new approaches are essential.
Eucalyptus species were the most common nectar source for the harvested honey, followed by tea trees (Leptospermum) and paperbark (Melaleuca).
The findings showed how the antimicrobial potency of honey is influenced by its floral source, and how Australia’s native flora gives it a chemically distinct nectar. The results show how restoration of local biodiversity and healthy bee populations can boost honey’s healing power.
“Our study shows that the antibacterial properties of honey are closely tied to ecological richness,” says lead researcher Dr Kenya Fernandes.
“Each nectar has its own unique chemical signature. When bees can forage on a smorgasboard of native plants, the mix combines to create honey chemically rich in bioactive compounds that are effective against bacteria.
“Locally produced Australian honey has real potential to compete on the world stage and in our fight against antibiotic resistance. This work shows why investing in bee health and bushfire recovery matters – not just environmentally, but medically and economically.
Honey is particularly promising because bacteria struggle to develop resistance to it. Its antimicrobial activity comes from multiple chemical mechanisms acting at once rather than a single drug target.
“Bees are crucial pollinators and play an invaluable role in our agricultural industry. We need to support local beekeepers as the industry is immensely struggling with bushfires, floods, and now the varroa mite,” says the research’s co-author Professor Dee Carter.
“As the Australian honey industry rebuilds from recent bushfire impacts, these insights suggest that prioritising ecosystem diversity could unlock enhanced honey bioactivity.”
The team is now investigating how honey can be used to treat fungal skin infections in both companion animals and humans, manage chronic urinary tract infections and heal burn wound infections.
Dr Fernandes is an Australian Research Council DECRA Fellow in the School of Life and Environmental Sciences at the University of Sydney. She is also a member of the Sydney Infectious Diseases Institute and the Centre for Drug Discovery Innovation.
Multimedia

Australia; NSW; VIC; QLD
Australia; NSW; VIC; QLD



